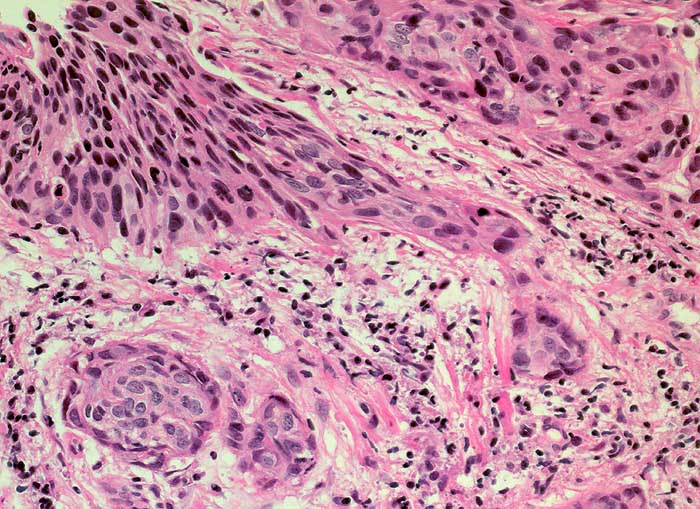

PathoPic – image database / PathoPic ID 6386 - gering verhornendes Plattenepithelkarzinom
de
Diagnose
gering verhornendes Plattenepithelkarzinom
Diagnose Gruppe
maligner Tumor
Topographie
Portio
Topographie Gruppe
Genitalorgane, weiblich
Beschreibung
Links im Bild Carcinoma in situ des Plattenepithels. Ausgehend von diesem Epithel zieht ein zapfenförmiger Tumorausläufer in die Tiefe. Ausserdem ein kugeliges Tumorinfiltrat umgeben von desmoplastischem Stroma.
Klinik
Dauerblutung seit 2 Wochen, deutlich gefässinjizierte Ektopie, sofortige Kontaktblutung.
Bilder Typ
Histologie
Vergrösserung
200
Alter
83
Geschlecht
unbekannt
Datum
Ersteintrag: 11.02.2003
Update: 10.08.2010